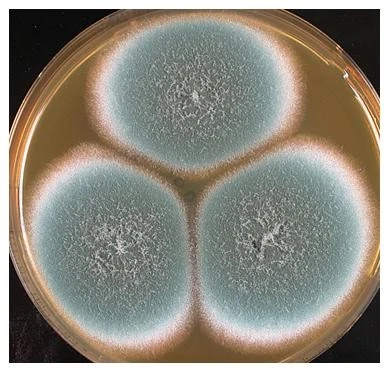
43iUd017svc1qkkktfjyl09d_e8dztr.png?type=e1920_std

놓쳐버린 논문의 추억
남들이야 관심도 가지지 않지만, 한번씩 꺼내보며 스스로 만족해하는 물건들이 있다. 공부를 하는 학자들에게 논문이 그런 물건 중의 하나가 아닌가한다.
과거에 쓴 논문 중의 하나가 드디어 200회 이상 인용되었다. 매년 20여 회씩 인용되면서 10년을 지나왔으니 대견하지 않을 수 없다. (Science의 논문이 평균 1년에 18회 인용된다.)
 10여년 전에 쓴 논문이 200여회 인용되었다.
10여년 전에 쓴 논문이 200여회 인용되었다.10여년전으로 되돌아 간다.
2005년 2월의 겨울날. 서호에서 아침 달리기를 마치고 싸늘한 버섯과 건물 3층 연구실에 들어와 컴퓨터를 켰다. 세계미생물학회연합의 IJSEM 논문사로부터 한통의 메일이 와 있었다.
‘당신이 투고한 논문과 같은 결과가 이미 게재를 앞두고 있기에 게재를 거부합니다.’
아, 한 발 늦었구나!
 연기아스페곰팡이, Aspergilus fumigatus
연기아스페곰팡이, Aspergilus fumigatusAspergillus fumigatus는 농업적으로는 유기물 분해균으로, 의학적으로는 인체병원균으로 알려진 경제적으로 매우 중요한 곰팡이다. 2002년부터 주요작물의 경작지 토양 곰팡이를 조사하면서 이 곰팡이에 관심을 가졌고, 지난 2년의 연구결과 이 중요한 곰팡이가 하나의 종이 아니라 형태적으로는 구분되지는 않으나 분자적으로는 구분되는 두 개의 종으로 구성이 되어 있다는 것을 발견하였다.
부푼 가슴으로 새로이 발견된 곰팡이 종을 new fumigatus라는 뜻으로 Aspergillus neofumigatus sp. nov. 라 이름 짓고 2004년 초에 논문을 쓰고 10월에는 일본 쯔구바의 세계미생물자원센터연맹학회(ICCC10)에 포스터발표까지 하였다.
 ICCC10 포스터 발표, 일본 JCM의 Ken Okata 박사와 A. neofumigatus 협의 중
ICCC10 포스터 발표, 일본 JCM의 Ken Okata 박사와 A. neofumigatus 협의 중
하지만 실상 논문투고는 빠르게 진행되지 못했다. 이 분야의 최고 석학인 Robert Samson 박사와 논문 진행을 협의하였는데 서로 바쁜 일로 투고가 늦추어져 2005년 1월에나 세계미생물학회연합 발간 논문인 IJSEM에 투고하였다.
그런데 이미 다른 학자가 같은 내용을 먼저 투고하여 게재를 앞두고 있다니......,
 간발의 차로 먼저 신종을 보고한 미국 질병관리센터의 A. Balajee 논문
간발의 차로 먼저 신종을 보고한 미국 질병관리센터의 A. Balajee 논문이 새로운 곰팡이를 먼저 보고한 학자는 미국의 질병관리센터(CDC)의 Arun Balajee 박사였다. 그녀는 오래전부터 A. fumigatus에 관한 연구를 하였으며 A. fumigatus 내에 약제 저항성이 다른 그룹이 존재한다는 것을 2004년에 이미 학계에 보고하였다. 이어 그녀는 약제 저항성이 다른 이 그룹을 신종으로 판단하고 A. fumigatus에 비하여 늦게 자란다고 하여 늦다라는 뜻을 가진 lentulus라고 명명하고 미국미생물학회의 Eukaryotic cell에 투고하였다.
Balajee 박사가 이 그룹을 신종으로 판단한 것이 언제인지는 정확히 알 수 없으나 그녀는 신종 논문을 2004년 11월 29일에 투고하였고 05년 1월에 게재 승인을 받았으며 3월에 게재하였다.
이렇게 상대는 급박하게 일을 진행시키고 있었는데 우물안 개구리인 나는 2004년 초에 새로운 fumigatus라는 뜻으로 neofumigatus라고 이름을 지어 놓고 논문까지 써 놓았으나 제출도 않고 10월 11일에 ICCC10 학회에서 발표까지 하는 여유를 부렸으니.....,
(이 때 나는 박사학위도 하지 않은 곰팡이 분류의 신출내기였다.)

(2007 Aspergillus workshop 네덜란드, 앞줄 우측부터 Machida, 나, Balajee 박사. 이 때에 Balajee 박사와 많은 이야기를 나누었으나 ICCC10에서 내가 발표한 포스터 초록을 봤었는지는 물어보지 않았다. 이미 지나간 일이니......,)
결국 나의 연구결과는 쓸모없는 것이 되어 버리고 말았다. 나는 상심이 컸다. 인류에 끼치는 영향이 매우 큰 곰팡이 신종을 처음으로 발견하였음에도 결과 발표의 미숙으로 놓치고......,
그렇다고 그냥 물러날 수도 없었다.
이미 A. lentulus로 미운 이름이 붙은 곰팡이지만 내가 많은 정을 주었고 Balajee 박사가 발견하지 않은 많은 데이터를 가지고 있었다. 하는 수 없이 A. fumigatus, A. lentulus 그리고 연관된 종들의 데이터를 묶어서 'A. fumigatus 와 연관된 종들의 다상 분류‘ (Polyphasic taxonomy of Aspergillus fumigatus and related speices)라는 제목으로 논문 투고하였다.
 저자의 박사학위 논문의 주요 논문인 Asp. fumigatus 와 연관된 종들의 다상 분류. 이 분야 연구의 모델을 제시하였다.
저자의 박사학위 논문의 주요 논문인 Asp. fumigatus 와 연관된 종들의 다상 분류. 이 분야 연구의 모델을 제시하였다.이렇게 내게 아픈 상처를 준 논문이었는데, 10여년이 지난 지금은 201번이나 인용이 되면서 내가 가장 아끼는 논문 중의 하나가 되었다.
뭣 때문에?
이 논문은 A. fumigatus에 포함되었던 중요 신종인 A. lentulus는 놓쳤지만 농업적으로 의학적으로 중요한 A. fugmigatus와 연관된 종들에 대한 종합적인 분류방법을 제시하였다. 특히 기존에는 형태적 방법에 의존하였으나 분자적 방법과 화학적 방법을 함께 적용한 다상 분류를 제시하여 향후의 많은 Aspergillus 속의 다상분류의 표준 모델이 되었다.
또 하나는 이 논문에서 Aspergillus의 분자분류로 calmodulin 유전자를 사용하면서 프라이머 Cmd5, Cmd6를 새로 개발하였다. 이 후 calmodulin 유전자가 Aspergillus 분류의 표준유전자가 되었고 프라이머 cmd5, cmd6도 Aspergillus 분류의 표준 프라이머가 되었다. 따라서 이 논문은 Aspergillus의 분류와 동정을 다룬 논문에는 꼭 인용되었다.
 저자의 논문이 Aspergillus 분류의 표준 유전자와 프라이머가 되었다.
저자의 논문이 Aspergillus 분류의 표준 유전자와 프라이머가 되었다.그 때에 신종을 놓친 아쉬움에 그냥 주저 앉았다면 ......,
일단은 하는 데까지 끝까지 최선을 다하고 볼일이다.
(추신)
Balajee 박사의 A. lentulus 논문은 오늘 날짜로 제 논문보다 100회도 더 많은 306회나 인용되었다.
10년전의 일인데도 이 논문을 보면 아직도 속이 쓰리다 ^-^.
(2017. 4. 10. 작성, 5. 7. 수정)